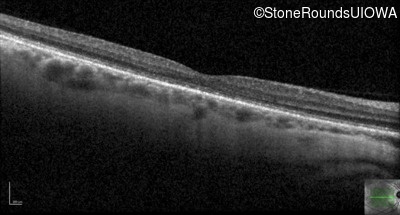
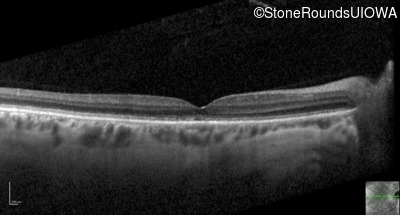
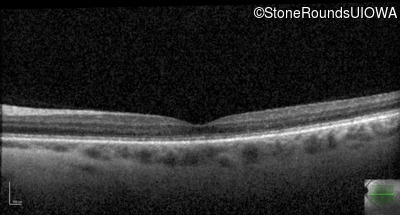
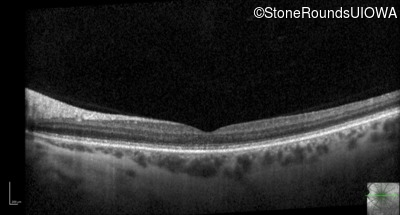
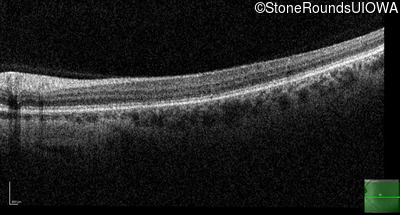
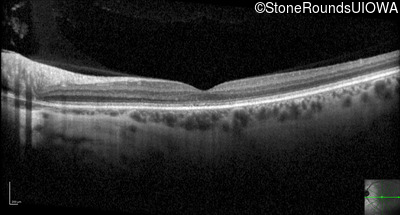

Case
SR1740
Student Mode
AD Cone and Cone Rod Dystrophy (IA1bii)
Male
Male
Hidden
SR1740
Student Mode
AD Cone and Cone Rod Dystrophy (IA1bii)
Male
Male
Please Login or Register to download images or create a PowerPoint slideshow.
Visit at age: 17 years
Goldmann Visual Field - Right - 20/30
Exemplar

Goldmann Visual Field - Left - 20/30 -2
Exemplar

Visit at age: 32 years
Fundus Photography - Right - 20/40
Exemplar

Fundus Photography - Left - 20/25
Exemplar

Fundus Montage - Right - 20/40
Exemplar

Fundus Montage - Left - 20/25
Exemplar

Goldmann Visual Field - Right - 20/40
Exemplar

Goldmann Visual Field - Left - 20/25
Exemplar

Optical Coherence Tomography - Right - 20/40
Exemplar / OCT Stack

OCT Stack

OCT Stack

Optical Coherence Tomography - Left - 20/25
Exemplar / OCT Stack

OCT Stack

OCT Stack

Infrared Fundus Photograph - Right - 20/40
Exemplar

Infrared Fundus Photograph - Left - 20/25
Exemplar

Blue Autofluorescence - Right - 20/40
Exemplar

Blue Autofluorescence - Left - 20/25
Exemplar

Visit at age: 34 years
Goldmann Visual Field - Right - 20/40
Exemplar

Goldmann Visual Field - Left - 20/25
Exemplar

Optical Coherence Tomography - Right - 20/40
Exemplar / OCT Stack

OCT Stack

OCT Stack

Optical Coherence Tomography - Left - 20/25
Exemplar / OCT Stack

OCT Stack

OCT Stack

Infrared Fundus Photograph - Right - 20/40
Exemplar

Infrared Fundus Photograph - Left - 20/25
Exemplar

Case Level Images
Please Login or Register to download images or create a PowerPoint slideshow.